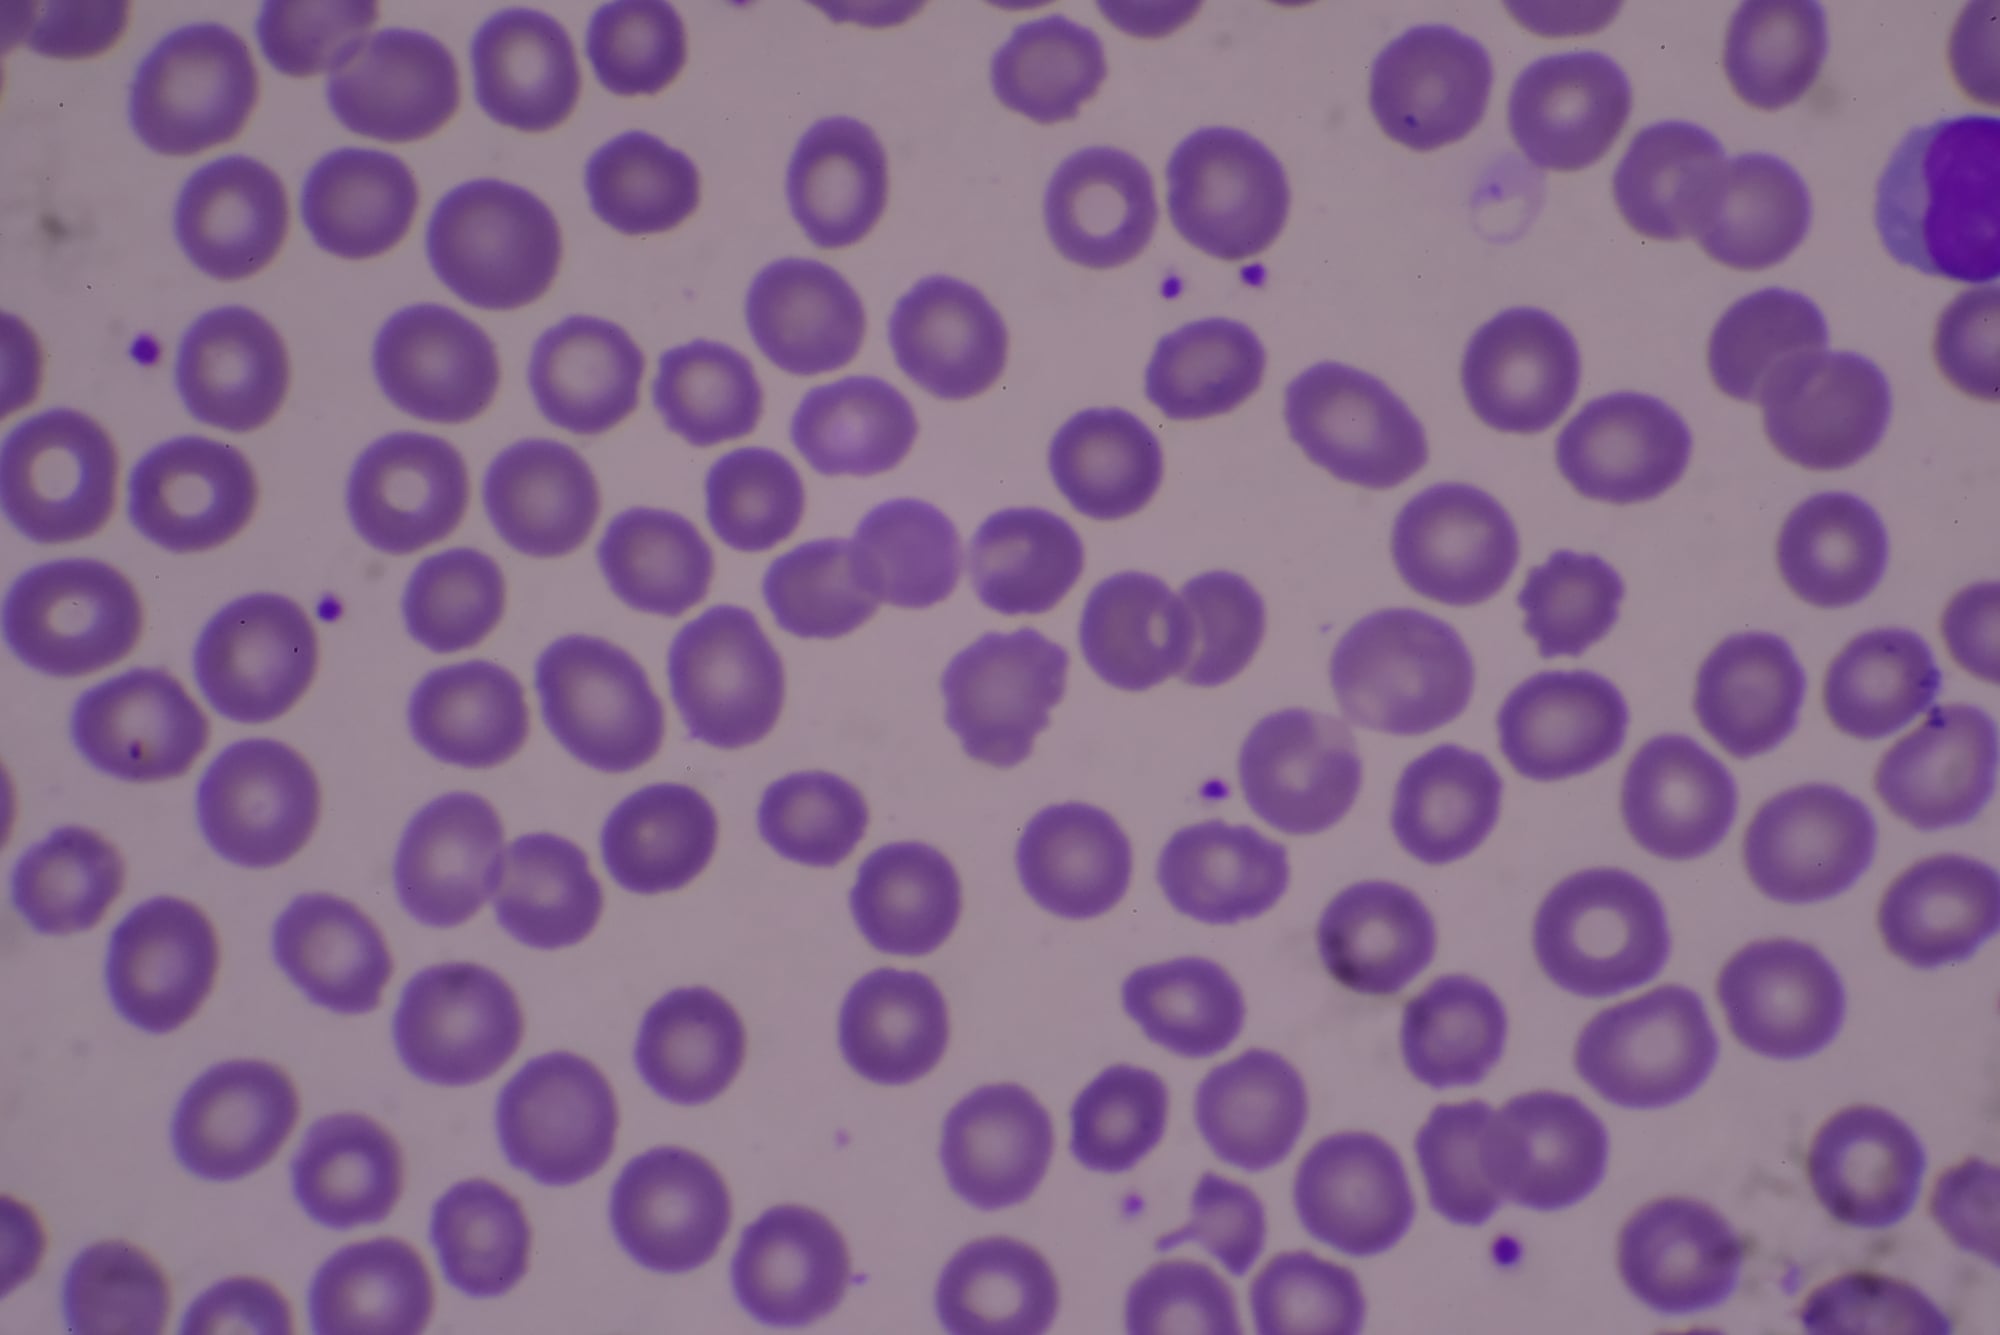

14 People Who Refused to Be Forgotten
History often tries to erase those who challenge the status quo. Yet some individuals fought so fiercely against the current that their legacies remain firmly etched in our collective memory. Their determination transformed obstacles into opportunities and limitations into launching pads for remarkable achievements.
Here is a list of 14 remarkable individuals whose refusal to be silenced or sidelined ensured their place in history.
Hedy Lamarr

Known to the world as a glamorous movie star of the s and s, Lamarr harbored an exceptional mind for engineering. During World War II, she co-invented a frequency-hopping system designed to guide torpedoes without detection.
Her groundbreaking work laid the foundation for modern technologies like WiFi, GPS, and Bluetooth—inventions most people use daily without knowing the Hollywood actress behind them.
Ignaz Semmelweis

This Hungarian physician discovered the life-saving importance of handwashing in medical settings decades before germ theory was established. His colleagues ridiculed him mercilessly when he suggested doctors should wash their hands between examining cadavers and delivering babies.
Despite facing professional ostracism that eventually broke him, Semmelweis’s practice now saves countless lives and forms the cornerstone of modern medical sanitation.
Like Go2Tutors’s content? Follow us on MSN.
Ada Lovelace

In an era when women were actively discouraged from scientific pursuits, Lovelace became the world’s first computer programmer in the s. She wrote the first algorithm intended to be processed by Charles Babbage’s Analytical Engine, essentially creating computer programming a century before computers existed.
Her notes included concepts so advanced they wouldn’t be rediscovered until the s, making her a visionary whose ideas transcended her time.
Nikola Tesla

The brilliant engineer gave us alternating current electricity that powers our homes today, yet died nearly penniless in a New York hotel room. Thomas Edison often overshadowed Tesla, taking credit for innovations that rightfully belonged to the Serbian inventor.
Despite corporate forces attempting to minimize his contributions, Tesla’s revolutionary ideas in wireless technology and electrical engineering have experienced a remarkable resurrection in public consciousness.
Henrietta Lacks
Without her knowledge, doctors harvested Lacks’s cancer cells in, creating the immortal HeLa cell line that continues to multiply in laboratories worldwide. These cells have been instrumental in developing vaccines, cancer treatments, and countless medical breakthroughs.
For decades, her contribution went unacknowledged while pharmaceutical companies profited enormously from her cells, yet persistent advocacy from her family eventually brought her extraordinary legacy to light.
Like Go2Tutors’s content? Follow us on MSN.
Alan Turing

The mathematician and computer pioneer cracked the Nazi Enigma code during World War II, likely shortening the conflict by years and saving millions of lives. Instead of receiving hero status, Turing faced criminal prosecution for his homosexuality and was forced to undergo chemical castration by the British government.
His reputation has since been restored with a posthumous pardon, and he’s now celebrated as the father of computer science and artificial intelligence.
Rosalind Franklin

Franklin captured the crucial X-ray diffraction images that revealed DNA’s double-helix structure, yet Watson and Crick used her work without proper credit when they published their groundbreaking paper. Her photographs provided the essential evidence for their model, which earned them a Nobel Prize while Franklin’s contribution remained in the shadows.
Modern scientific historians have worked tirelessly to ensure her fundamental role in one of science’s greatest discoveries is properly recognized.
Bayard Rustin

A master strategist of the civil rights movement, Rustin organized the March on Washington where Martin Luther King Jr. delivered his ‘I Have a Dream’ speech. As an openly gay man in an intensely homophobic era, he was often forced to work behind the scenes to avoid damaging the movement.
His unyielding advocacy for nonviolence and equality shaped American history, even when others received the spotlight for his organizational brilliance.
Like Go2Tutors’s content? Follow us on MSN.
Emmy Noether

Einstein called her the most important woman in the history of mathematics, yet Noether taught for years without pay because German universities wouldn’t officially hire female professors. Her theorem connecting symmetry and conservation laws fundamentally transformed modern physics and mathematics.
Despite institutional barriers at every turn, her intellectual force was so undeniable that even the most rigid academic establishments eventually had to acknowledge her revolutionary contributions.
Madam C.J. Walker

Born to former slaves just after the Civil War, Walker built a hair care empire that made her America’s first female self-made millionaire. Her products specifically addressed the needs of Black women whom the beauty industry completely ignored.
She employed thousands of Black women as sales agents, creating economic opportunities when few existed, and used her fortune to fund anti-lynching campaigns and educational scholarships when such activism carried serious risks.
Chien-Shiung Wu

Known as the ‘First Lady of Physics,’ Wu disproved a fundamental law of physics (the principle of conservation of parity) that had been considered unshakable. Despite conducting the critical experiment, she was excluded from the Nobel Prize awarded to her male colleagues for the discovery.
Her precision experiments helped develop the atomic bomb and advanced the understanding of beta decay, cementing her legacy as one of history’s most meticulous experimental physicists.
Like Go2Tutors’s content? Follow us on MSN.
Pauli Murray

Decades before Rosa Parks, Murray was arrested for refusing to move to the back of a bus. This brilliant legal mind wrote papers that later became the foundation for Thurgood Marshall’s arguments in Brown v. Board of Education.
Murray also co-founded the National Organization for Women and became the first African American woman ordained as an c. Their work connecting race and gender discrimination laid the groundwork for legal concepts still evolving today.
Claudette Colvin

Nine months before Rosa Parks’s famous arrest, 15-year-old Colvin refused to give up her seat on a Montgomery, Alabama bus. Civil rights leaders decided not to use her case to challenge segregation laws because she was unmarried and pregnant.
For decades, her pivotal role remained largely unknown despite being a plaintiff in Browder v. Gayle, the Supreme Court case that actually ended bus segregation in Montgomery.
Fanny Mendelssohn

The older sister of composer Felix Mendelssohn wrote over 450 pieces of music, many initially published under her brother’s name because women weren’t taken seriously as composers. Her father told her music should be ‘an ornament’ for her but never a profession, yet she persisted in creating extraordinary compositions.
Modern musicians have revived interest in her work, recognizing its technical brilliance and emotional depth that stands proudly alongside the recognized masters of her era.
Like Go2Tutors’s content? Follow us on MSN.
Echoes Across Time

These remarkable individuals show how determination can transcend even the most entrenched barriers of prejudice and circumstance. Their stories remind us that history isn’t just written by the victors—it’s also preserved by those stubborn enough to demand their rightful place.
Today’s recognition of these previously marginalized figures demonstrates how persistent truth eventually finds its way into our shared narrative, enriching our understanding of human achievement.
More from Go2Tutors!

- 18 Unexpectedly Valuable Collectibles You Might Have Lying Around
- 20 Little-Known Historical Battles That Had Huge Consequences
- 20 Historical Artifacts That Scientists Can’t Explain
- 15 Inventions That Were Immediately Banned After Being Created
- 20 Actors Who Were Almost Cast in Iconic Roles
Like Go2Tutors’s content? Follow us on MSN.



